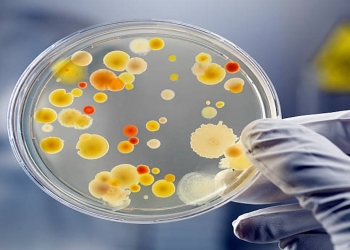
microbi (pexels)

Tutti gli articoli
Pranzo di Ferragosto 2024, gli esperti: “Sì a piatti freschi e di stagione”/ “Evitare le grigliate”
Pranzo di Ferragosto: i consigli degli esperti per non rinunciare ai piaceri della tavola senza trascurare l'importanza di una sana ...
Cina, primato mondiale sull’energia atomica/ Ora sorpassa gli Usa: avanti di anni sulla quarta generazione
La Cina sta correndo verso il primato di produzione dell'energia atomica. Secondo gli esperti entro il 2030 supererà Francia e ...
Norvegia, figlio principessa ereditaria arrestato per aggressione/ Vittima la donna con cui aveva relazione
Poca chiarezza sulla presunta aggressione che vede responsabile il figlio della principessa ereditaria di Norvegia, Mette-Marit.
Centri migranti Albania, il resoconto di Piantedosi: “Costano 160mln all’anno”/ “Meno arrivi e più rimpatri”
Al centro del question time alla Camera i centri migranti in Albania. Piantedosi ha riportato alcuni dati: forte calo di ...
Stop vaccini Covid alle donne in gravidanza/ Ricerca USA: troppi casi di morte fetale e aborto dopo iniezione
Sulle donne in gravidanza e in allattamento è stato dimostrato che i vaccini Covid causano aborto e morte fetale.
Olimpiadi, qual è età d’oro in atletica leggera?/ Awosoga: “Picco 27 anni: dopo diminuiscono prestazioni”
Fissata a 27 anni l'età media in cui viene raggiunto il picco delle prestazioni in atletica leggera alle olimpiadi: questa ...
Decreto Liste d’attesa è legge/ Novità: via a piattaforma nazionale monitoraggio e visite anche nei weekend
Il Decreto Liste d'Attesa è ufficialmente legge. Molte le novità introdotte per ridurre il problema dei lunghi tempi d'attesa per ...
Germania: stop sussidi su energie rinnovabili da gennaio 2025/ Incertezze sugli investimenti futuri nel green
Sussidi sulle energie rinnovabili: la Germania dice 'stop' dal 1° gennaio 2025 stando al recente progetto di legge di bilancio ...
Migranti, Sahara più mortale del Mediterraneo/ Rapporto ONU: “Oltre 1000 morti negli ultimi 3 anni”
Emerge una grande omertà sui migranti che muoiono attraversando il deserto del Sahara, che sembra avere più insidie e pericoli ...
Torture alla CRI di Roma, maltrattati 2 pazienti con ritardi mentali/ “Una galleria degli orrori”
Arrestati 10 operatori socio-sanitari CRI per maltrattamenti e torture consumate ai danni di 2 pazienti affetti da seri ritardi mentali. ...
I microbi sono amici, solo pochi ci danneggiano/ Gli esperti: “Fondamentali per la vita, proteggiamoli”
Novità sui microbi: secondo alcuni esperti la maggior parte sarebbero nostri amici, e addirittura potrebbero anche servirci per salvarci la ...
Patto Putin-Kim Jong-un: Corea del Nord con la Russia contro Usa/ Ecco cosa dice il “patto di mutua difesa”
Tra Putin e Kim Jong-Un è stato firmato un patto di mutua difesa che lascia presagire che vi sia anche ...
Procedura d’infrazione UE contro l’Italia: troppo deficit/ Cosa succede ora: “non si torna all’austerità”
Annunciata la procedura d'infrazione UE nei confronti dell'Italia per deficit eccessivo. Deve essere ancora definito con precisione il piano di ...
Piano di sicurezza cure, report OMS: solo il 30% dei paesi lo ha/ Ad oggi danni per 1 paziente su 10
Il recente report OMS si è concentrato sulla necessità di implementare la sicurezza delle cure dei pazienti a livello mondiale. ...
Stonehenge, lanciata vernice arancione da sui monoliti/ Arrestati due ecovandali dalla polizia britannica
Nuovo blitz degli ecoattivisti: stavolta ad essere colpite sono state le pietre di Stonehenge. Due degli ecovandali sono stati prontamente ...
Roberta Calvano (costituzionalista) choc a La7/ “Premierato? Rischiamo Totti o un influencer come premier”
Proseguono gli scontri sulla riforma del premierato. A schierarsi contro troviamo anche la costituzionalista Roberta Calvano, che ha spiegato le ...
Aviaria USA, triplicati allevamenti bovini infetti e 500 persone monitorate/ OMS: “Rischio salute basso”
Avanza la diffusione dell'aviaria negli Usa: l'OMS tranquillizza dichiarando che il rischio per la salute pubblica è basso.
Crisi climatica? Studio internazionale va contro tendenza/ Prof. Scafetta: “Surriscaldamento sarà moderato”
Clima e surriscaldamento globale: siamo davvero in emergenza? Il Prof. Scafetta, con uno studio internazionale smonta ogni punto che i ...
Milano, in primavera la pioggia tocca il record da 128 anni/ Ma Marzo è stato più caldo degli ultimi 30 anni
Temperatura di poco superiore alla media ma pioggia oltre la norma nella primavera milanese: così tante precipitazioni non cadevano da ...
Mamma a 63 anni con la fecondazione in vitro in Ucraina/ Parto cesareo d’urgenza: il bimbo pesa quasi 2Kg
Una donna toscana di 63 anni è diventata mamma all'età di 63 anni grazie alla fecondazione assistita a Kiev, in ...
Anticiclone Scipione, arriva ondata di caldo su tutta l’Italia/ Picchi vicini ai 40 gradi fino al weekend
Anticiclone africano Scipione in arrivo in tutta Italia: picchi di 40 gradi al Sud e massime di 35 gradi al ...
Ministro della difesa tedesco “entro il 2029 pronti alla guerra”/ “Presto nuove forme di servizio militare”
Il ministro della difesa tedesco Pistorius ha annunciato che entro il 2029 potrebbe scoppiare una guerra mondiale. E così il ...
Lotta a denatalità: la soluzione è nel desiderio di avere figli/ Roccella: “Essere genitori torna un valore”
La ministra Eugenia Roccella, nel suo editoriale su Il Giornale, riflette sui positivi segnali, tratti dai dati Istat, del desiderio ...
Klaus Schwab si è dimesso dalla presidenza esecutiva WEF/ Chi è l’economista teorico del “Grande Reset”
Klaus Schwab ha annunciato il suo ritiro ufficiale dalla carica di presidente esecutivo del World Economic Forum 8WEF). Brende il ...
Minori autori di reati, presto possibili i lavori pubblica utilità/ Pronto accordo Tribunale-Comune di Milano
Nel breve termine verrà dato il via al progetto che sottoporrà i minori autori di reato ai lavori di pubblica ...
Case popolari Lombardia: nuovi criteri per assegnazioni/ Più punti in graduatoria a disabili, anziani, minori
Delibera della Regione Lombardia con le nuove direttive sull'assegnazione delle case popolari: maggiore punteggio in graduatoria per lacune categorie di ...
Cecità ereditaria, primi risultati positivi tecnica CRISPR/ Pennesi: “è solo l’inizio ma risultati eccitanti”
Sta dando risultati sorprendenti la tecnica CRISPR, capace di incidere sulla mutazione genetica responsabile di una forma di cecità ereditaria, ...
Ansia post-pandemia giovani: colpa dei ‘super-genitori’/ Andreoli: “Adolescenti hanno smesso di trasgredire”
Ansia nei giovani: la colpa sarebbe da ricercare nei 'super-genitori' di oggi, incapaci di imporsi e di dispensare dei 'no', ...
Auto elettriche in crisi? Costano troppo ai costruttori/ Mercedes e Ford restano su motori termici
Cambia tutto sul fronte auto elettriche: gli elevati costi che pesano sui costruttori stanno costringendo ad un cambio di passo, ...
Crediti bonus ai sanitari per il 2026-2028: la formazione sui vaccini premia/ Delibera della Commissione ECM
Crediti bonus per i sanitari che si formeranno in materia di vaccini. La Commissione ECM ha rinnovato questa previsione anche ...